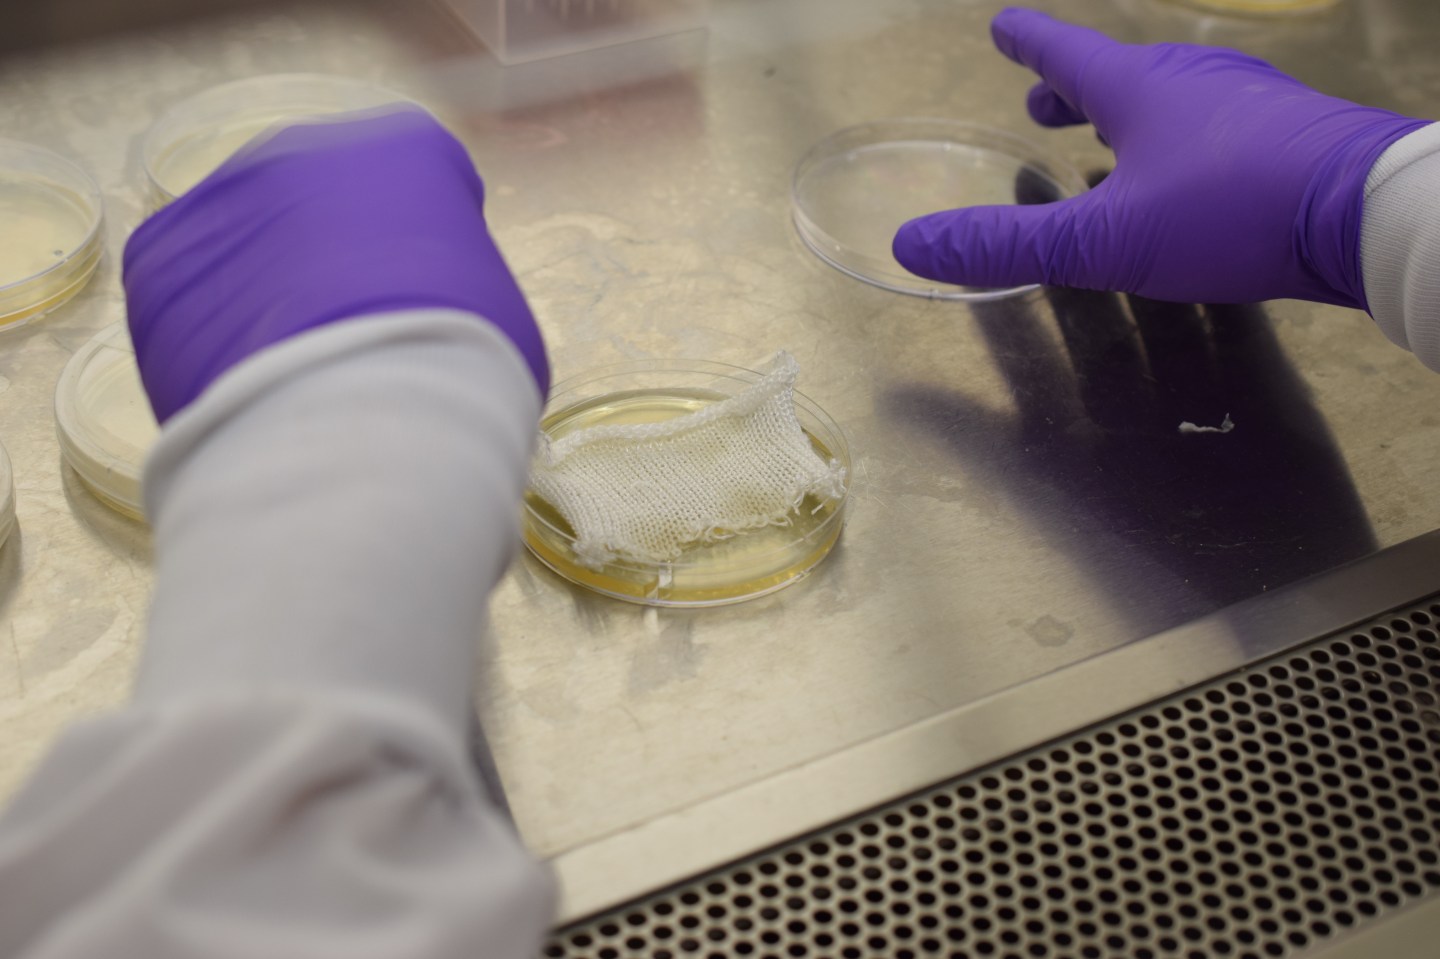
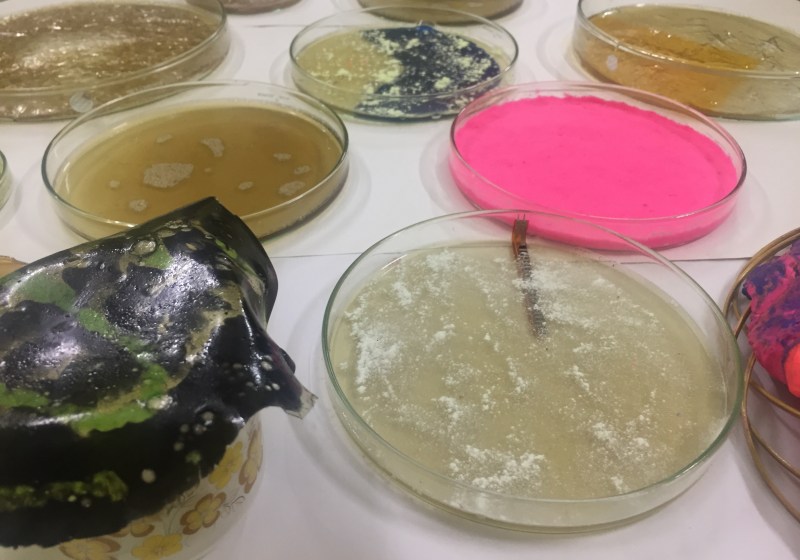

„I am passionate in designing experiences and fabricating material interfaces that embed computation into physical materials to enhance and achieve more seamless interactions with the environment around us. As wearable or inside the body systems, I like to think of these interfaces as novel medical platforms that change the way we heal and treat the human body in the days to come.